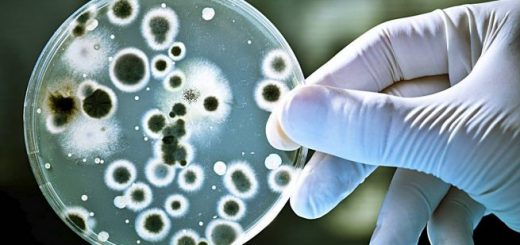

En la actualidad es la enfermedad crónica más común en el planeta, y afecta al 80% de la población mundial
Una reciente recomendación realizada por la Organización Mundial de la Salud (OMS) sugiere disminuir el consumo de calorías provenientes de azúcares del 10% (cifra establecida desde el 2002) al 5% de la ingesta diaria. Incluso una reducción mayor del consumo de azúcar tendría beneficios adicionales. Un 5% de la ingesta calórica total equivale a unos 25 gramos (aproximadamente 6 cucharadas pequeñas) de azúcar al día para un adulto con un índice de masa corporal normal.
Gran parte de los azúcares que consumimos, existentes en los alimentos procesados, son una de las causas de la aparición de caries en todo el mundo, reveló la OMS en el borrador de una consulta pública sobre directrices de la ingesta de azúcares.
«Existe una creciente preocupación respecto de que el consumo de azúcares puede dar como resultado un aumento de la ingesta calórica total, dando lugar a una dieta poco saludable, aumento de peso corporal y aumento del riesgo de caries», expresó la OMS en un comunicado.
En la Argentina, cerca del 83% de los niños de 5 años tienen caries y presentaron un promedio de 5,4 dientes con caries; a los 12 años, tienen 4,9 dientes afectados; y los adultos de entre 25 y 44 años presentaron un promedio de 4,7 dientes con caries, de acuerdo a las cifras que arrojó un relevamiento realizado en la Ciudad Autónoma de Buenos Aires por docentes de la cátedra de Odontología Preventiva y Comunitaria de la Facultad de Odontología de la UBA.
La caries es una enfermedad multifactorial que genera la destrucción de los tejidos del diente, como consecuencia de la desmineralización provocada por los ácidos generados por la placa bacteriana a partir del azúcar. Todos los días la placa bacteriana se forma sobre los dientes y las bacterias metabolizan los alimentos, en especial los carbohidratos (azúcares y almidones), formando ácidos que desmineralizan el esmalte del diente, iniciando así el proceso de la caries.
El proceso metabólico, resultado de la descomposición de los azúcares de los alimentos que ingerimos, genera un ambiente ácido y aumenta el pH del medio bucal. Esto condiciona la presencia de un ambiente cariogénico en la boca, siendo éste el principal factor para la aparición y progresión de las lesiones de caries.
«La caries es una enfermedad que se puede controlar y prevenir, por lo que el desarrollo de nuevas tecnologías y productos que ayudan a la detección, prevención y tratamiento temprano de lesiones de caries constituyen un constante desafío para la profesión y la industria», aclara el estudio.
Implicaciones sociales de la caries dental
Esta importante enfermedad afecta no sólo a los niños en edad escolar sino también a la gran mayoría de los adultos. Desafortunadamente, en etapas tempranas la caries no produce síntomas y el signo inicial, que es una mancha blanca, no es fácil de visualizar para el paciente. Por ello, el diagnóstico o control profesional cada seis meses es tan importante para prevenir y controlar este tipo de lesiones tempranas o incipientes.
Un síntoma tardío de la caries es el dolor dental y constituye causa de ausentismo laboral y escolar. Este dolor refleja que el grado de compromiso y destrucción del diente ha llegado a la pulpa o nervio dental y que el tratamiento será más complejo y costoso.
Fuente: Infobae